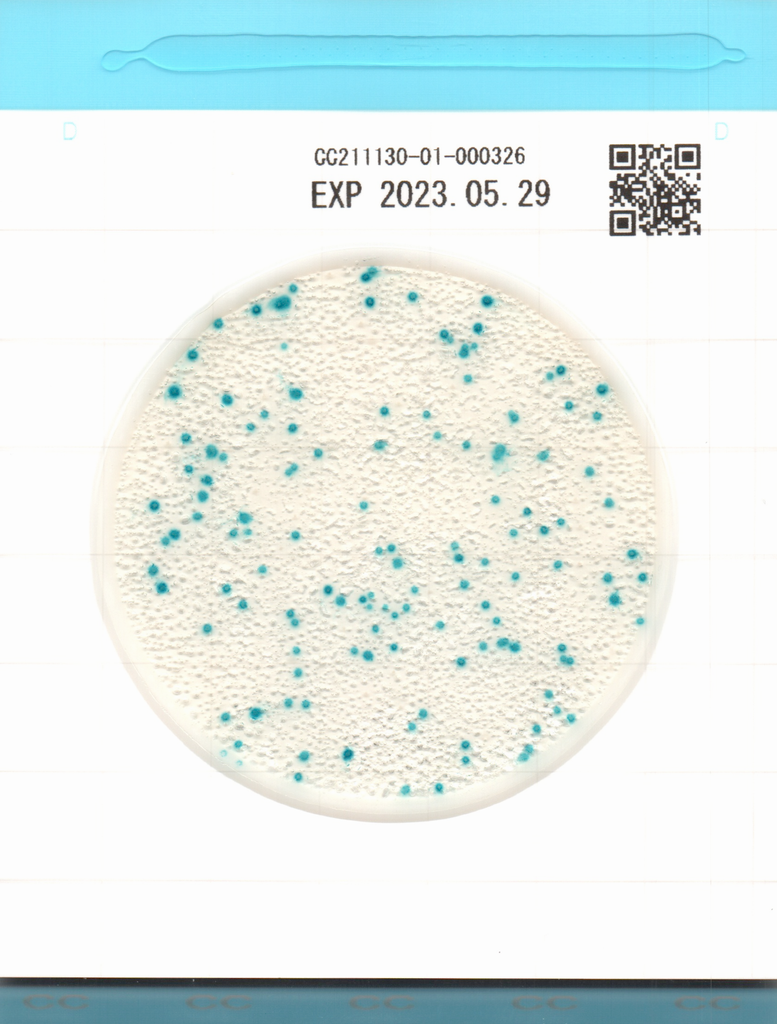

Easy Plate CC
- Einfache Handhabung, zuverlässige Ergebnisse
- AOAC PTM-zertifiziert
- Hohe Spezifität
- Sofort einsatzbereit, Probensuspension auf die Platte geben und inkubieren
- Sehr geringer Platzbedarf beim Inkubieren und wenig Abfall
Selbstdiffundierend, präzise, zertifiziert (AOAC-PTM, MicroVal), REDUZIERT Platz, Zeit und Abfall. Für Coliforme
Easy Plate CC ist eine mikrobiologische Plattenmethode, die aus einem wasserdichten Papier mit einem vorgefertigten Trockenmedium und einer transparenten Abdeckung über dem Medium besteht. Die Easy Plate CC-Methode dient zur Bestimmung des Gehalts an coliformen Bakterien in Lebensmitteln und ist eine Alternative zur Violet Red Bile Agar-Methode im Bacteriological Analytical Manual der U.S. Food and Drug Administration (FDA BAM): Enumeration of Escherichia coli and the Coliform Bacteria.
Die Platten sind kompakt, einfach in der Anwendung und reduzieren die Gesamtabfallmenge, die bei der Verwendung des Tests entsteht. Die Easy-Plate-CC-Methode wurde vom AOAC Research Institute als 'Performance Tested Methods SM' (für rohes, gemahlenes Schweinefleisch, rohe Lampen, rohes, gemahlenes Hühnerfleisch, rohes Thunfischfilet, rohes Lachsfilet, rohe Garnelen, frische, geschälte Bananen, frisch geschnittene Ananas und frisch geschnittene Äpfel), anerkannt.
Für die Vorbereitung der Platten zum Inkubieren sind keine zusätzlichen Hilfsmittel erforderlich. Dies ist dem hydrophoben Ring, um die Kulturfläche zu verdanken, der beim automatischen Verteilen der Probe auf der Kulturfläche hilft.
1x 100 Platten/Packung
Ziel-Mikroorganismen: Coliforme Bakterien
Artikel Nummer: 61974
Inkubationszeit: 24 Stunden ± 1 Stunden
Inkubationstemperatur: 35°C ± 1°C
Lagerfähigkeit: 18 Monate nach Herstellung
Lagerung: 2-8°C
Bereiten Sie die Probe gemäß der Anleitung vor.
Nehmen Sie 1 ml der Probenlösung mit einer Pipette auf und klappen Sie den Deckel der Platte auf. Pipettieren Sie die Probenlösung auf die Platte und schließen Sie den Deckel.
Entsprechend der Anleitung inkubieren.
- Easy Plate CC CC20260305A exp 04.09.2027.pdf
- Easy Plate CC CC20260206A exp 05.08.2027.pdf
- Easy Plate CC CC20260205A exp 04.08.2027.pdf
- Easy Plate CC CC20251202A exp 01.06.2027.pdf
- Easy Plate CC20251111A exp 10.05.2027.pdf
- Easy Plate CC CC20251007A exp 06.04.2027.pdf
- Easy Plate CC CC20250801A exp 31.01.2027.pdf
- Easy Plate CC CC20250310A exp 09.09.2026.pdf
- 61974_CC20250108A.pdf
- 61974_CC20250107A.pdf
- 61974_CC20250106A.pdf
- 61974_CC20241113A.pdf
- 61974_CC20241108A.pdf
- 61974_CC20240822A .pdf
- 61974_CC20240821A .pdf
- Easy Plate CC CC20240822A exp 21.02.2026 .pdf
- Easy Plate CC CC20240821A exp 20.02.2026 .pdf
- Easy Plate CC CC20240617A 16.12.2025.pdf
- Easy Plate CC CC20240613A exp 12.12.2025.pdf
- Easy Plate CC CC20240404A exp 03.10.2025.pdf
- Easy Plate CC - CC20240110A - exp 09.07.2025.pdf
- Easy Plate CC - CC20231208A - exp 07.06.2025.pdf
- Easy Plate CC - CC20231207A - exp 06.06.2025.pdf
- Easy Plate CC - CC20231120A - exp 19.05.2025.pdf
- Easy Plate CC - CC20231117A - exp 16.05.2025.pdf
- Easy Plate CC - CC20231018A - exp 17.04.2025.pdf
- Easy Plate CC - CC20230921A - exp 20.03.2025.pdf
- Easy Plate CC - CC20230919A - exp 18.03.2025.pdf
- Easy Plate CC - CC20230904A - exp 03.03.2025.pdf